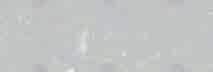
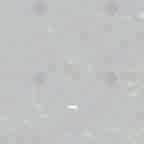
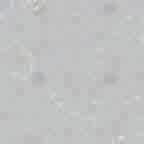
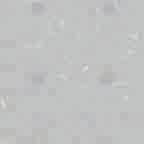
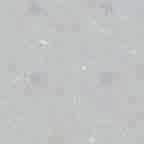
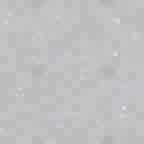
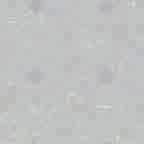
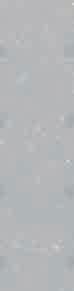
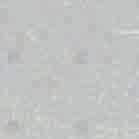
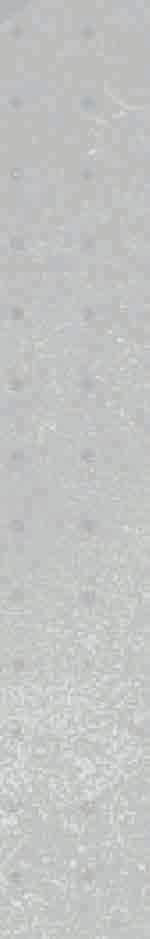

![]()




































FALL/WINTER 2025























































marcó la introducción del color en el fútbol. Fructuoso López lanzó en los años noventa las primeras botas de color. Dejaron de ser negras para teñirse de otros colores y revolucionar para siempre el terreno de juego.
The turning point in the company’s growth was marked by the introduction of color in football. Fructuoso López launched the first colored boots in the 1990s. They stopped being black to be dyed in other colors and

“EN 1965 FUNDÉ JOMA CON EL COMPROMISO DE DEDICARLE A LA EMPRESA TODO MI ESFUERZO, TIEMPO Y CARIÑO. 50 AÑOS DESPUÉS, ESO ES EXACTAMENTE LO QUE HACEMOS”
“In 1965 founded Joma, with the commitment to devote all of my effort, time and affection to the company. 50 years later, that is exactly what we do.”
In 2017, Joma implements new robotic machinery in its international logistics warehouse with the aim of streamlining work, from product storage to package preparation for shipment worldwide. It manages to deliver 87% of sales before the scheduled date, reducing the margin of error




En 2017 Joma implementa una nueva maquinaria robótica en su almacén logístico internacional con el objetivo de agilizar el trabajo, desde el almacenamiento de los productos hasta la preparación de paquetes para enviar a cualquier parte del mundo. Consigue entregar un 87% de las ventas antes de la fecha prevista, that all its technologies are proprietary. Quality is its reason for being.

procedentes de 12 países, incluyendo España, Portugal, Marruecos, Jordania, Kazajistán, Honduras, Malta y At the Tokyo 2020 Olympic Games, Joma outfits over 1,500 athletes from 12 countries, including Spain, Portugal, Morocco, Jordan, Kazakhstan, Honduras, Malta, and

















Fermín Cacho gana el oro olímpico en la final de 1500m en Barcelona 1992 calzando unas Joma.



Lanzamiento de la Joma vuelve a los JJOO en Tokio 2020 con la presencia de Jesús Ángel García Bragado






Primeras zapatillas de running de Joma Antonio Ricardo Lanzamiento de la primera zapatilla de competición la R-4000.





Joma tiene presencia en la Diamond League de Bruselas con la zapatilla R-5000 en la prueba de la hora.


Joma renueva las R-4000 y lanza las R-2000, una de sus zapatillas más exitosas, que posteriormente ganará el premio a la año por la revista






































En los últimos años, Joma ha intensificado su inversión en I+D+i con el objetivo de integrar tecnología avanzada en sus productos, respondiendo así a las crecientes demandas del mercado deportivo y de los consumidores. La marca ha sido capaz de destinar cada vez más recursos hacia el desarrollo de nuevos materiales y procesos de fabricación que optimizan la funcionalidad y el rendimiento de su calzado. Esta exploración de nuevas fronteras tecnológicas ha hecho posible que cada deportista y atleta encuentre en las zapatillas el aliado perfecto para superar sus límites.










El departamento de desarrollo trabaja en profundidad cada día del año para optimizar la ergonomía y el rendimiento del calzado, teniendo en cuenta las necesidades de cada deporte y contando con la colaboración y la experiencia de atletas profesionales. Las exhaustivas pruebas biomecánicas que realizan nuestros profesionales garantizan una mayor comodidad y rendimiento en cada pisada. En el ámbito del running y trail running, estos estudios se enfocan en ofrecer un calzado que proporcione la máxima amortiguación y reactividad con la introducción de sistemas tan novedosos como la placa de fibra de carbono CARBON PLATE, que mejora la eficiencia en carrera mientras el corredor ahorra energía.













CALZADO RUNNING

SOPORTE / Neutro

USO / IntervalosCompetición
DROP / 6mm PESO / 177g



AMORTIGUACIÓN / Voladora
AMORTIGUACIÓN /
Equilibrada

SOPORTE / Ligero
USO / Entrenamiento diarioCompetición

DROP / 10mm PESO / 245g




AMORTIGUACIÓN / Máxima
SOPORTE / Neutro

USO / Entrenamiento largosRecuperación
DROP / 8mm PESO / 262g


















































































AMORTIGUACIÓN /
Equilibrada

SOPORTE / Neutro

USO / Competición (5Km-10Km)
DROP / 6mm PESO / 247g









SOPORTE / Neutro




AMORTIGUACIÓN / Voladora

USO / Competición (10Km-21Km)
DROP / 6mm PESO / 260g







AMORTIGUACIÓN / Máxima
SOPORTE / Neutro
USO / Tempo Run-
Competición (21Km-42Km)

DROP / 7mm PESO / 250g

DANIELA FRA /

ATLETA PROFESIONAL








AMORTIGUACIÓN /
SOPORTE /

















Ligero




Material ultrarreactivo y ligero, que consigue un excelente retorno de energía para optimizar el rendimiento, reducir la fatiga y ayudar a la recuperación muscular. En las R-6000, este compuesto garantiza una zapatilla cómoda y reactiva para correr durante largas distancias.









Máxima


USO / Entrenamiento largos-Recuperación





DROP / 8mm


PESO / 262g

























El sistema diseñado para proporcionar una estabilidad excepcional en la zona central y trasera del pie. Esta pieza rígida se integra en la estructura del calzado, evitando torsiones indeseadas durante la carrera y mejorando el control en cada paso. Su diseño ergonómico se adapta al movimiento natural del pie, ofreciendo soporte sin sacrificar la flexibilidad. VTS



Tecnología avanzada incorporada en el upper de las zapatillas, mejora la transpirabilidad y el confort, enfocándose en permitir una ventilación óptima, reduciendo la acumulación de calor dentro de la zapatilla. Gracias a sus materiales ligeros y a su diseño especializado, el VTS no solo aligera la zapatilla, sino que también asegura que el pie se mantenga fresco y cómodo durante todo tu entrenamiento o competición.































RR600W2502













































RR600W2510








































La mediasuela combina dos compuestos para ofrecer un rendimiento excepcional. En la parte trasera, el Fly Reactive proporciona un excelente retorno de energía y una propulsión eficiente, optimizando cada zancada. En la parte delantera, un Phylon de última tecnología aporta mayor estabilidad y reactividad, mejorando el control y la adaptabilidad en cada paso. Juntos, estos compuestos garantizan un aterrizaje suave y una respuesta dinámica, brindando un equilibrio perfecto entre comodidad y rendimiento.



AMORTIGUACIÓN / Equilibrada
SOPORTE / Ligero







CARLA ARCE / ATLETA PROFESIONAL DROP /






10mm

USO / Entrenamiento diario-Competición

PESO / 245g











Tecnología avanzada incorporada en el upper de las zapatillas, mejora la transpirabilidad y el confort, enfocándose en permitir una ventilación óptima, reduciendo la acumulación de calor dentro de la zapatilla. Gracias a sus materiales ligeros y a su diseño especializado, el VTS no solo aligera la zapatilla, sino que también asegura que el pie se mantenga fresco y cómodo durante todo tu entrenamiento o competición


La suela proporciona un agarre excepcional y una durabilidad prolongada. Hecha de caucho de alta calidad, maximiza la tracción y reduce el riesgo de deslizamientos. Su diseño distribuye


























RR200W2502







































RR200W2510


















MIGUEL ÁNGEL LÓPEZ / CAMPEÓN DEL MUNDO 20KM MARCHA




















Material ultrarreactivo y ligero, que consigue un excelente retorno de energía para optimizar el rendimiento, reducir la fatiga y ayudar a la recuperación muscular.

En las R-4000, este compuesto garantiza una zapatilla ultraligera y reactiva para poder exprimirte al máximo.


AMORTIGUACIÓN / SOPORTE /



Voladora

Neutro

USO / Intervalos-Competición
DROP / 6mm

PESO / 177g
















Tecnología avanzada incorporada en el upper de las zapatillas, mejora la transpirabilidad y el confort, enfocándose en permitir una ventilación óptima, reduciendo la acumulación de calor dentro de la zapatilla. Gracias a sus materiales ligeros y a su diseño especializado, el VTS no solo aligera la zapatilla, sino que también asegura que el pie se mantenga fresco y cómodo durante todo tu entrenamiento o STABILIS

Sistema integrado en la suela de la zapatilla proporciona una estabilidad excepcional, evitando torsiones indeseadas durante la

Esta pieza rígida se integra para ofrecer soporte en la zona central del pie, mejorando el control




































































































quienes se inician en este tipo de calzado y para entrenamientos de alta intensidad. Su flexibilidad permite una transición más natural en la pisada, mejorando la comodidad y adaptabilidad. Además, ofrece la propulsión necesaria para optimizar el rendimiento, lo que la convierte en una opción versátil para diversos entrenamientos y competiciones.




SOPORTE / Ligero





AMORTIGUACIÓN / Máxima


USO / Tempo Run-Competición (21Km-42Km








DROP / PESO / 7mm 250g
















Compuesto en la mediasuela de las zapatillas que junto con placa de carbono está diseñado para ofrecer un equilibrio perfecto entre amortiguación y reactividad. Este material ligero proporciona una excelente absorción de impactos, lo que ayuda a reducir la fatiga durante tus competiciones. Además, su capacidad de retorno de energía maximiza el efecto de la placa de carbono mejorando la propulsión en cada zancada.



Tecnología avanzada incorporada en el upper de las zapatillas, mejora la transpirabilidad y el confort, enfocándose en permitir una ventilación óptima, reduciendo la acumulación de calor dentro de la zapatilla. Gracias a sus materiales ligeros y a su diseño especializado, el VTS no solo aligera la zapatilla, sino que también asegura que el pie se mantenga fresco y cómodo durante todo tu entrenamiento o competición





































































































La placa de carbono de la R-3000 proporciona un rendimiento excepcional al maximizar la propulsión en cada zancada. Su estructura rígida optimiza la transferencia de energía, permitiendo una zancada más rápida y eficiente. Esta tecnología minimiza la fatiga muscular al reducir el esfuerzo necesario en cada carrera, lo que permite a los corredores mantener su rendimiento durante más tiempo.


SOPORTE / Neutro




AMORTIGUACIÓN / Voladora



DROP / 6mm




260g USO / PESO /




Competición (10Km-21Km)













Compuesto en la mediasuela de las zapatillas que junto a la placa de carbono está diseñado para ofrecer un equilibrio perfecto entre amortiguación y reactividad. Este material ligero proporciona una excelente absorción de impactos, lo que ayuda a reducir la fatiga durante tus competiciones. Además, su capacidad de retorno de energía maximiza el efecto de la placa de carbono mejorando la propulsión en cada zancada.




Tecnología avanzada incorporada en el upper de las zapatillas, mejora la transpirabilidad y el confort, enfocándose en permitir una ventilación óptima, reduciendo la acumulación de calor dentro de la zapatilla. Gracias a sus materiales ligeros y a su diseño especializado, el VTS no solo aligera la zapatilla, sino que también asegura que el pie se mantenga fresco y cómodo durante todo tu entrenamiento o competición


















































RR300W2502





RR300W2510

















/ 02:10:37 MARATHON PERSONAL BEST




















La placa de carbono de la R-5000 proporciona un rendimiento excepcional al maximizar la propulsión en cada zancada. Su estructura rígida optimiza la transferencia de energía, permitiendo una zancada más rápida y eficiente. Esta tecnología minimiza la fatiga muscular al reducir el esfuerzo necesario en cada carrera, lo que permite a los corredores mantener su rendimiento durante más tiempo.
SOPORTE /








AMORTIGUACIÓN / Equilibrada





USO / Competición (5Km-10Km) DROP / PESO / Neutro 6mm 247g























Compuesto en la mediasuela de las zapatillas que junto a la placa de carbono está diseñado para ofrecer un equilibrio perfecto entre amortiguación y reactividad. Este material ligero proporciona una excelente absorción de impactos, lo que ayuda a reducir la fatiga durante tus competiciones. Además, su capacidad de retorno de energía maximiza el efecto de la placa de carbono mejorando la propulsión en cada zancada.


Tecnología avanzada incorporada en el upper de las zapatillas, mejora la transpirabilidad y el confort, enfocándose en permitir una ventilación óptima, reduciendo la acumulación de calor dentro de la zapatilla. Gracias a sus materiales ligeros y a su diseño especializado, el VTS no solo aligera la zapatilla, sino que también asegura que el pie se mantenga fresco y cómodo durante todo tu entrenamiento o competición.
























































































































- 3000mm columna de agua








- 150gr








- Costuras termoselladas





- Elementos reflectantes






- Transpirable























































La tecnología de impermeabilidad con 3000 mm de columna de agua ofrece una buena protección contra la entrada de agua, manteniéndote seco en condiciones de lluvia.. Además, su diseño transpirable permite la evaporación del sudor y la humedad interna, manteniendo una sensación de confort y frescura. Así, obtienes una combinación ideal de protección contra el agua y regulación de la temperatura,









Este chubasquero de 3000 mm incluye aperturas en los costados y la espalda para maximizar la transpirabilidad. Su diseño permite una excelente circulación del aire, evitando la acumulación de calor y humedad. Ideal para actividades intensas, combina impermeabilidad con comodidad, asegurando un uso fresco y seco.



















Da igual la oscuridad de la ciudad, esta prenda cuenta con elementos reflectantes diseñados para mejorar tu visibilidad. Estos detalles reflectantes aumentan la seguridad, haciéndote más visible para otros corredores, o conductores durante tus actividades nocturnas o en ambientes con poca luz. La incorporación de estos elementos en puntos clave de la prenda garantiza una mayor protección, ayudando a prevenir accidentes.






















































R-NIGHT























- Ligereza


El interior perchado aporta una capa suave y cálida, proporcionando confort adicional y ayudando a mantener el calor en temperaturas frías. Además, mejora la sensación al contacto con la piel, haciendo que la prenda sea muy








- Cortavientos







- Impermeable





- Transpirable







- Elementos reflectantes










































Las aperturas para los dedos permiten un ajuste firme de las mangas, evitando desplazamientos y manteniendo las manos parcialmente cubiertas. Esto es ideal para los días fríos, ya que brinda una protección extra sin necesidad











Las aberturas laterales mejoran la ventilación, permitiendo que el aire circule libremente durante la carrera. Esto ayuda a regular la temperatura corporal y reduce la acumulación de calor en sesiones intensas.





















































- Tejido ligero.

- Adaptable a la anatomía corporal.
- Elementos reflectantes.









- Transpirable en zonas estratégicas.














- Copas Extraibles.
- Elementos reflectantes.



- Adaptable a la anatomía corporal.















- Compresión.



- Media Sujeción.

















Materiales altamente transpirables, permiten una rápida evaporación del sudor, manteniendo la piel seca y evitando el sobrecalentamiento en entrenamientos de alta intensidad.










































Estas prendas incorporan diferentes detalles reflectantes que aumentan la visibilidad en condiciones de poca luz, mejorando la seguridad durante entrenamientos al aire libre al amanecer o al anochecer. Estos elementos están colocados estratégicamente para garantizar que seas visible desde diferentes ángulos.




Diseño ligero y cómodo ideal para ejercicios que requieren movilidad completa. El top cuenta con la espalda abierta tipo nadador que no solo mejora la transpirabilidad al permitir mayor ventilación, sino que también facilita el movimiento de los omóplatos, haciéndolo perfecto para actividades que involucran los brazos. Los tirantes finos permiten mayor libertad de movimiento en los brazos y hombros, sin sacrificar soporte.





















































- Tejido ligero









- Adaptable a la anatomía corporal














Materiales altamente transpirables, permiten una rápida evaporación del sudor, manteniendo la piel seca y evitando el sobrecalentamiento en entrenamientos de alta intensidad.



- Elementos reflectantes
- Transpirable en zonas estratégicas



- Mallas con tejido compresivo









































































Estas prendas incorporan diferentes detalles reflectantes que aumentan la visibilidad en condiciones de poca luz, mejorando la seguridad durante entrenamientos al aire libre al amanecer o al anochecer. Estos elementos están colocados estratégicamente para garantizar que seas visible desde diferentes ángulos.
Ya sea tu elección la pantaloneta, que ofrece una excelente libertad de movimiento gracias a su corte amplio y materiales ligeros, permitiendo zancadas fluidas y dinámicas, o la malla, que mejora la circulación sanguínea y reduce la vibración muscular, disminuyendo la fatiga y favoreciendo una mejor recuperación durante entrenamientos intensos, ambas opciones son perfectas para maximizar tu rendimiento.





















